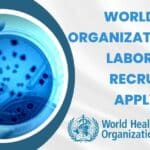
World Health Organization Job

Home Search
microbiology - search results
If you're not happy with the results, please do another search
IISER TVM Biology, Biotechnology JRF Job Opening, Applications Invited
IISER TVM Biology, Biotechnology JRF Job Opening, Applications Invited
IISER TVM Biology, Biotechnology JRF Job Opening, Applications Invited. IISER TVM is hiring Biology & Biotechnology...
CFTRI NON-NET MSc Candidates Apply Online For Project Position
CSIR-CFTRI MSc Non-NET Job For Microbiology, Apply Online
CSIR-CFTRI MSc Non-NET Job For Microbiology, Apply Online. CSIR-CFTRI Job Opening. MSc Microbiology Job. Interested and eligible...
Biotecnika Times Newsletter 19.01.2023 Project Interns Requires, Student Trainee With Monthly Pay
Biotecnika Times Newsletter 19.01.2023 Project Interns Requires, Student Trainee With Monthly Pay
Project Interns Recruitment at IISER Kolkata - BSc & MSc Candidates Apply
Project Interns...
ICMR-JALMA Research Job For Life Sciences, Attend Walk-In
ICMR-JALMA Research Job For Life Sciences, Attend Walk-In
ICMR-JALMA Research Job For Life Sciences, Attend Walk-In. ICMR JALMA Job openings. BSc & MSc Microbiology/Biochemistry/Biotechnology or...
Biocon KGI Certificate Program in Biosciences | Admission Open
Biocon KGI Certificate Program in Biosciences | Admission Open
Biocon Academy's flagship program, the Biocon KGI Certificate Program in Biosciences in partnership with Keck...
CSIR-IMTECH AcSIR PhD Program Admission August 2023 Session, Apply Online
CSIR-IMTECH AcSIR PhD Program Admission August 2023 Session, Apply Online
CSIR-IMTECH AcSIR PhD Program Admission August 2023 Session, Apply Online. CSIR-IMTECH PhD Admission August 2023....
Biotecnika Times Newsletter 17.01.2023 Freshers Jobs, Govt Internship, Ramalingaswamy Re-entry Fellowship
Biotecnika Times Newsletter 17.01.2023 Freshers Jobs, Govt Internship, Ramalingaswamy Re-entry Fellowship
Freshers Job Opening at SJRI For MSc Biotech, Life Sciences, Microbiology
Freshers Job Opening at...
IISER Mohali Project Associate Recruitment Under SERB-POWER Grant
IISER Mohali Project Associate Recruitment Under SERB-POWER Grant
IISER Mohali Project Associate Recruitment Under SERB-POWER Grant. M.Sc/B.Tech Life Sciences JRF job at IISER Mohali. Interested...
Biotecnika Times Newsletter 16.01.2023 UPSC, CCRAS-CARI, DST-INSPIRE Fellowship
Biotecnika Times Newsletter 16.01.2023 UPSC, CCRAS-CARI, DST-INSPIRE Fellowship
UPSC Biochem, Biology, Botany & Zoology Scientist Job Openings, Apply Online
UPSC Biochem, Biology, Botany & Zoology Scientist...
MAHE Manipal Mol Bio, Microbio, Cell Bio, Genetics, Biochem JRF Job Recruitment
MAHE Research Fellow Job For MSc Biochem, Cell Bio, Mol Bio
MAHE Research Fellow Job For MSc Biochem, Cell Bio, Mol Bio. Manipal Academy of...
Biotecnika Times Newsletter 13.01.2023 Freshers Trainee Jobs, Apprentice Jobs
Biotecnika Times Newsletter 13.01.2023 Freshers Trainee Jobs, Apprentice Jobs
Freshers Trainee Biotech Job at Bharat Serums and Vaccines, Apply Online
Freshers Trainee Biotech Job at Bharat...
RCB Engagement of Apprentice For Biotech Candidates With Stipend PM
RCB Hiring Biotech Apprentices With Monthly Stipend - Applications Invited
RCB Hiring Biotech Apprentices With Monthly Stipend - Applications Invited. Regional Centre for Biotechnology Engagement...
Coca Cola India Hiring Biochemistry Candidates, Apply Online For Lab Chemist
Coca Cola India Hiring Biochemistry Candidates, Apply Online For Lab Chemist
Coca Cola India Hiring Biochemistry Candidates, Apply Online For Lab Chemist. Coca Cola India...
World Health Organization AMR Laboratories Recruitment, Apply Online
World Health Organization Job Recruitment, Apply Online
World Health Organization Job Recruitment, Apply Online. World Health Organization Careers. WHO Jobs. Interested and eligible applicants can...
Coca Cola Lab Analyst Job For BSc Candidates, Online Application Process
Coca Cola Lab Analyst Job For BSc Candidates, Online Application Process
Coca Cola Lab Analyst Job For BSc Candidates, Online Application Process. Coca Cola India...